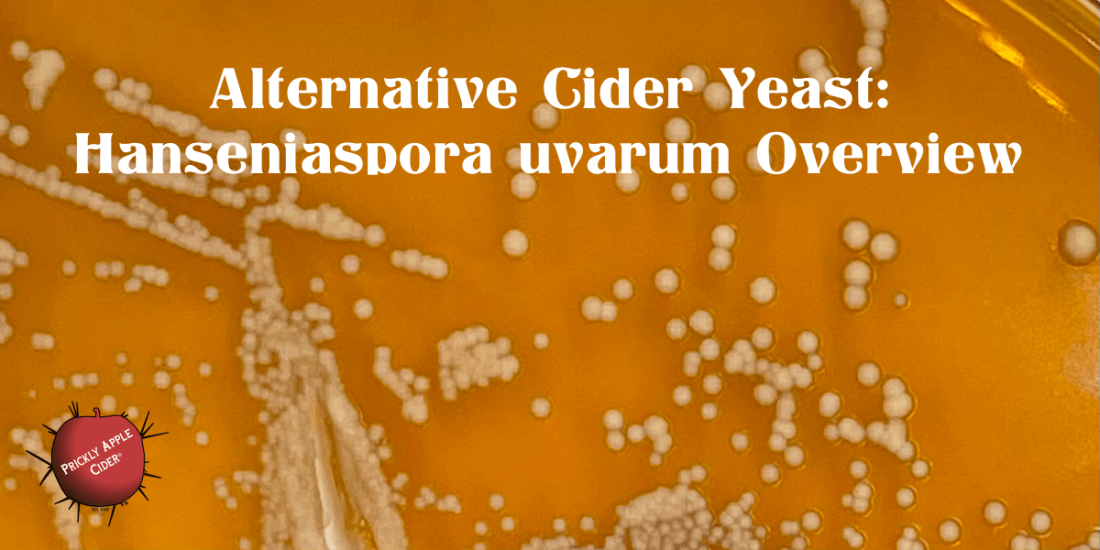
Alternative Cider Yeast: Hanseniaspora uvarum

Bucket with Film YeastYeast versus Mold: Yeast is the smooth white and mold is the fuzzy green/blackMold on top of Cider If you’ve read many of my articles, you know I often answer questions with “it depends”. However, that doesn’t mean we can’t define practices that are generally helpful and will not create problems when … Continue reading Cider Rules: Oxygen
Tag: Acetic
The Overview: Acetic Acid Bacteria
Acetic acid is generally considered one of the most undesirable compounds found in cider. In very small doses, it can have a positive impact but in general, it is something you should try to avoid because of the vinegary aroma and taste it can produce. You might think that the most common producer of acetic … Continue reading The Overview: Acetic Acid Bacteria
Volatile Acidity Versus Vinegar
Languages often have multiple words that can mean the same thing. They also have words that can mean many different things depending on the context or situation in which they are used. Saying it is chilly, cool, or brisk this morning basically means the same thing. You might want a jacket. The temperature is low. … Continue reading Volatile Acidity Versus Vinegar
Cider Facts: Sugar and Acetic Acid
Sugars impact on acetic acid production in wine. Did you know that the amount of sugar in your juice can impact the amount of acetic acid produced. As noted in the Handbook on Enology(1), wines with higher specific gravity produced more acetic acid when fermented with Saccharomyces cerevisiae yeasts. As shown in the above chart, … Continue reading Cider Facts: Sugar and Acetic Acid
Malolactic Fermentation and Citric Acid
Malolactic Fermentation or what is often referred to simply as MLF, is the process where lactic acid bacteria converts malic acid to lactic acid. For cider makers, MLF can be a very important process because apples are high in malic acid. As a result, MLF can reduce the acidity found in hard cider made from … Continue reading Malolactic Fermentation and Citric Acid
Sulfur Dioxide (SO2) Tolerance
Generalization of how tolerant various microorganisms are to free SO2. Sulfur dioxide (SO2) has the ability to weaken the cell walls of organisms resulting in their death or inability to function. It can also react and bind with phenolic and other compounds impacting color, sweetness, bitterness, and astringency. SO2 tolerance is the ability of an … Continue reading Sulfur Dioxide (SO2) Tolerance
Film Yeast – Flor – Pellicle
A layer or film formed by yeast on the top of hard cider when exposed to oxygen during storage. So you open the lid to your bucket or peer through the glass of your carboy and what do you find, some gnarly looking whitish film, crust, or even little island floating on the surface. What … Continue reading Film Yeast – Flor – Pellicle
Acetic Acid: How Cider Becomes Vinegar
Can hard cider go bad? You know, can cider spoil? I often see posts about someone who found an old bottle of cider they forgot and the question often asked is whether it’s safe to drink. The answer is usually, yes, it’s safe to drink. That is because hard cider won’t really spoil, it simply … Continue reading Acetic Acid: How Cider Becomes Vinegar
Alternative Cider Yeast: Hanseniaspora uvarum Overview
This is the second of the non-Saccharomyces cerevisiae yeast that I plan to explore next season. In my first post on alternative yeast for hard cider, I covered Lachancea thermotolerans. A yeast that was misclassified for over 70 years before being identified through gene sequencing in 2003. This post is about Hanseniaspora uvarum, which is … Continue reading Alternative Cider Yeast: Hanseniaspora uvarum Overview
Common Acids in Hard Cider
Apple and pear juice contain a variety of organic acids. Even sweet apples with high pH like Red Delicious and Ambrosia are still acidic. They won’t contain the same quantity as a tart and sharp Granny Smith or bittersharp cider apple, but they contribute to the hard cider flavors. When I assess apples for hard … Continue reading Common Acids in Hard Cider